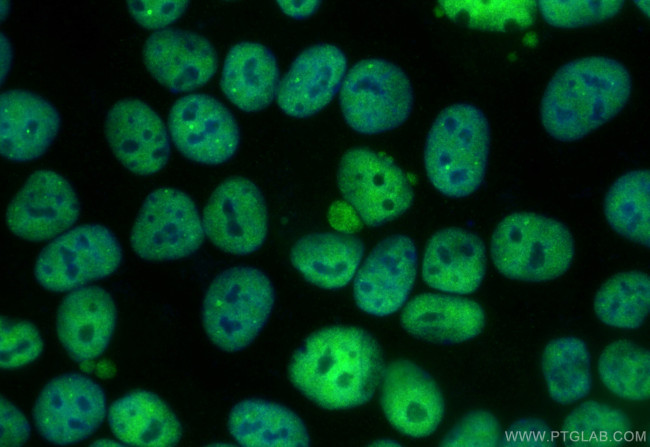
FIP1L1 Antibody in Immunocytochemistry (ICC/IF)

Search
Proteintech
FIP1L1 Recombinant Rabbit Monoclonal Antibody (240658A8), CoraLite® Plus 488
{{$productOrderCtrl.translations['antibody.pdp.commerceCard.promotion.promotions']}}
{{$productOrderCtrl.translations['antibody.pdp.commerceCard.promotion.viewpromo']}}
{{$productOrderCtrl.translations['antibody.pdp.commerceCard.promotion.promocode']}}: {{promo.promoCode}} {{promo.promoTitle}} {{promo.promoDescription}}. {{$productOrderCtrl.translations['antibody.pdp.commerceCard.promotion.learnmore']}}
产品信息
CL488-83863-3
种属反应
宿主/亚型
Expression System
分类
类型
克隆号
抗原
偶联物
激发/发射光谱
形式
浓度
纯化类型
保存液
内含物
保存条件
运输条件
产品详细信息
Sequence of this protein is as follows: MSAGEVERLV SELSGGTGGD EEEEWLYGDE NEVERPEEEN ASANPPSGIE DETAENGVPK PKVTETEDDS DSDSDDDEDD VHVTIGDIKT GAPQYGSYGT APVNLNIKTG GRVYGTTGTK VKGVDLDAPG SINGVPLLEV DLDSFEDKPW RKPGADLSDY FNYGFNEDTW KAYCEKQKRI RMGLEVIPVT STTNKITAED CTMEVTPGAE IQDGRFNLFK VQQGRTGNSE KETALPSTKA EFTSPPSLFK TGLPPSRNST SSQSQTSTAS RKANSSVGKW QDRYGRAESP DLRRLPGAID VIGQTITISR VEGRRRANEN SNIQVLSERS ATEVDNNFSK PPPFFPPGAP
靶标信息
FIP1L1 is a component of the cleavage and polyadenylation specificity factor (CPSF) complex that plays a key role in pre-mRNA 3'-end formation, recognizing the AAUAAA signal sequence and interacting with poly(A) polymerase and other factors to bring about cleavage and poly(A) addition. FIP1L1 contributes to poly(A) site recognition and stimulates poly(A) addition. It binds to U-rich RNA sequence elements surrounding the poly(A) site. FIP1L1 may act to tether poly(A) polymerase to the CPSF complex.
仅用于科研。不用于诊断过程。未经明确授权不得转售。
篇参考文献 (0)
生物信息学
蛋白别名: DKFZp586K0717; Factor interacting with PAP; FIP1 like 1; FIP1-like 1 protein; FIP1L1 cleavage and polyadenylation specific factor subunit; FLJ33619; hFip1; Pre-mRNA 3'-end-processing factor FIP1; Rearranged in hypereosinophilia
基因别名: FIP1; FIP1L1; hFip1; RHE
UniProt ID: (Human) Q6UN15
Entrez Gene ID: (Human) 81608